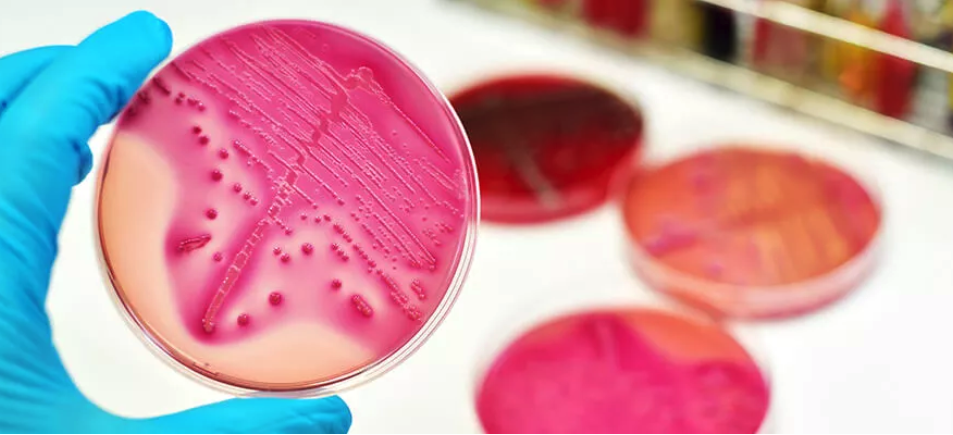

Life Scientist work in most parts of Australia, with Queensland and Western Australia having large shares of Life Scientist. They work mainly in the following sectors: Professional, Scientific and Technical Services; Education and Training; and Public Administration and Safety industries.
Minimum requirements for Life Scientist include bachelor’s degree and relevant work experience.

Biologist
ANZSCO ID 234511
Job Description
Research basic principles of plant and animal life, which includes the origin, relationship, development, anatomy, and functions.

Anatomist or Physiologist
Job Description
Research on form and structure of animal bodies
Specialisation
Embryologist
Neuroanatomist

Biochemist
ANZSCO ID 234513
Job Description
Research chemical composition and processes of living organisms that affect vital processes such as growth and aging
Specialisation
Enzyme Chemist
Protein Chemist

Biotechnologist
ANZSCO ID 234514
Job Description
Uses biological organisms to create and improve products and processes
Specialisation
Cell Geneticist
Molecular Biologist
Molecular Geneticist

Botanist
ANZSCO ID 234514
Job Description
Research on all aspects of life
Specialisation
Plant Morphologist
Plant Pathologist
Plant Physiologist
Plant Taxonomist

Marine Biologist
ANZSCO ID 234516
Job Description
Research, analysis, and forecasts in relation to the oceans, their life forms, and coastal areas
Microbiologist
ANZSCO ID 234517
Job Description
Research microorganisms and their behavior to resolve issues affecting our health, environment, climate, food, and agriculture
Specialisation
Bacteriologist (non-medical)

Zoologist
ANZSCO ID 234518
Job Description
Study animals and other wildlife, and how they interact with their ecosystems
Specialisation
Entomologist
Mammologist
Ornithologist

Other Life Scientist
Job Description
This occupation group covers Life Scientists not elsewhere classified. Occupations in this group include:
Specialisation
Animal Behaviourist
Parasitologist
Pharmacologist
Toxicologist
LATEST NEWS

Tapping Into South Australia’s Food Manufacturing Boom: A Guide for Production Operators and Employers
South Australia’s food and bevvy sector is absolutely humming. We’re known globally for top-shel...

How Konnecting Skilled Migration & Recruitment Is Solving Engineering & Trade Skill Shortages Across Major Projects
Claims the proposed $93 billion high-speed rail line from Newcastle to Sydney will result in the ...

National Press Club – Address by the Hon Tony Burke MP
MP Canberra, ACT, Oct 15, 2025 Attended by Fred Molloy, Registered Migration Agent.National Pres...

